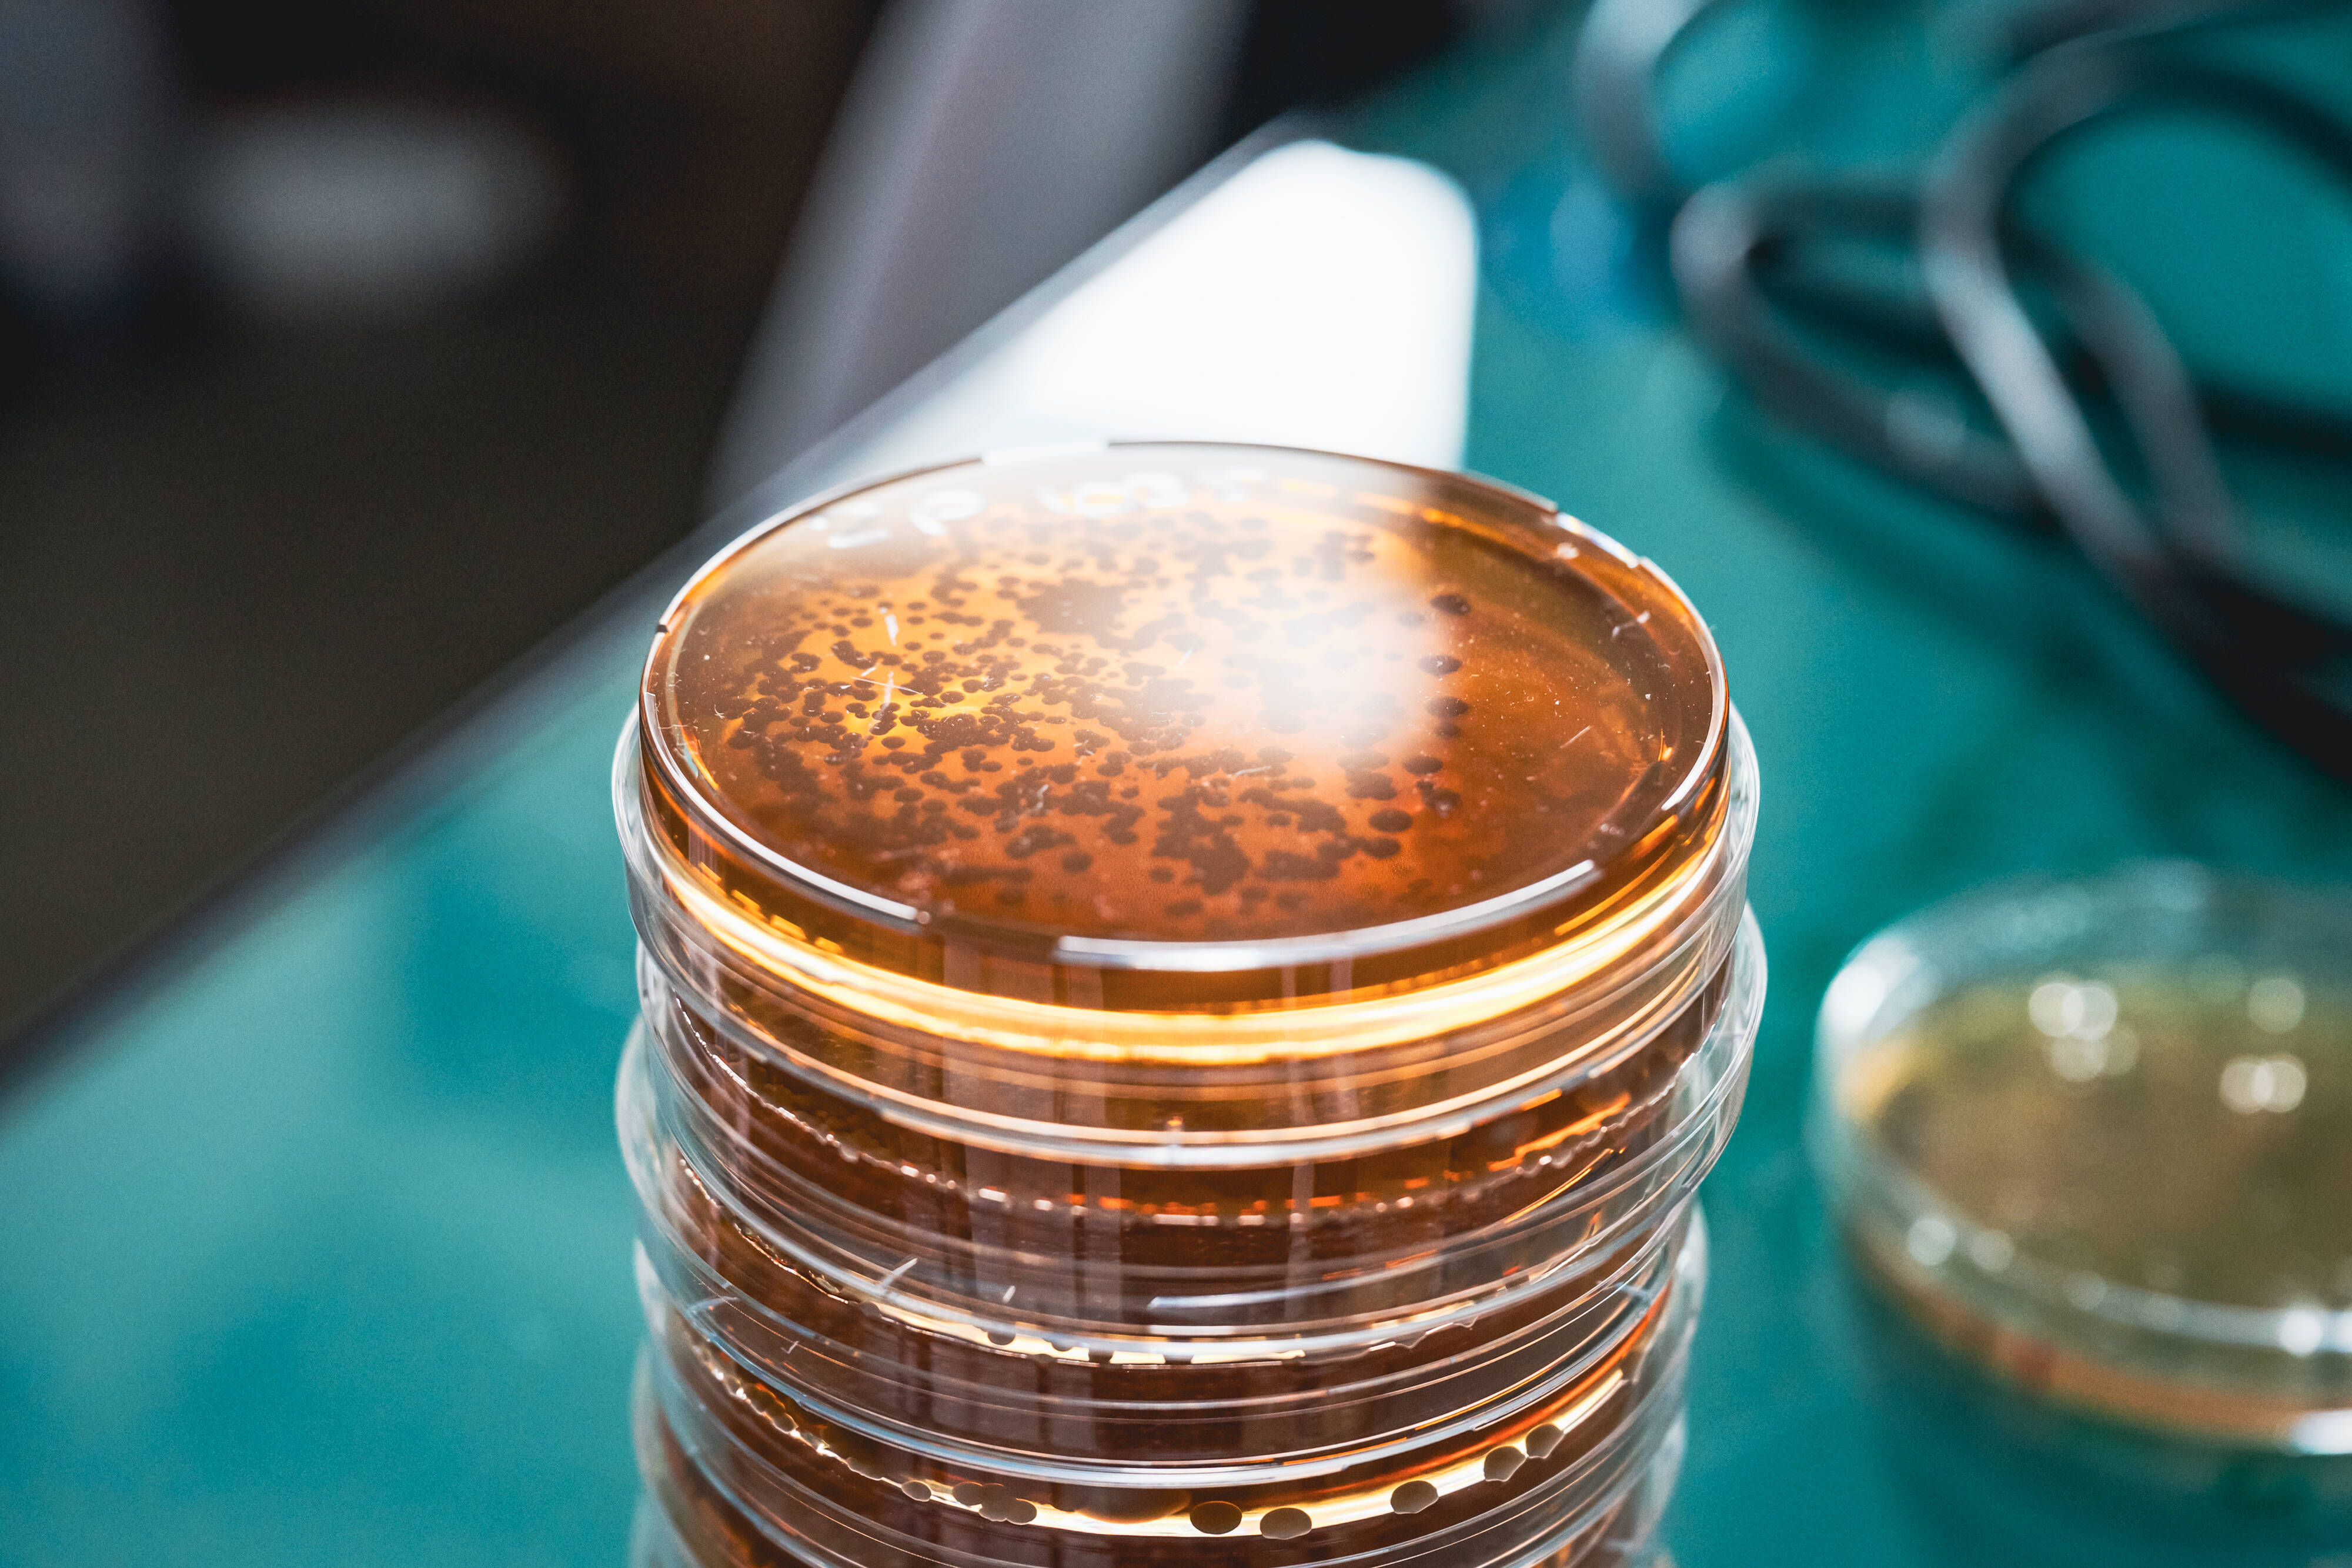
Le prix Impulscience revient à un Niçois pour ses recherches sur les mécanismes qui influencent l'évolution des espèces

Attentat antisémite de Sydney : "Tout le monde rêverait d'avoir un fils comme le mien", la mère de l'un des suspects refuse de le croire coupable et décrit son enfant comme un garçon sans histoires
"On va rester à la maison parce qu'il fait très chaud", avait indiqué le père et son fils à leur épo


/2025/10/21/075-pedersen-bayer04l251021-np2hj-68f7ec410d864386649807.jpg)